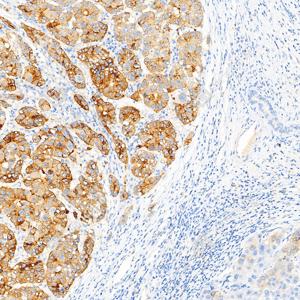
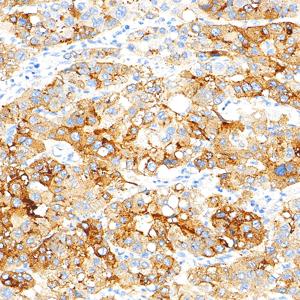

Recombinant Anti-Glypican 3 antibody (Mouse mAb)
- 100 μL
产品信息
蛋白质全称 | 磷脂酰肌醇蛋白聚糖3 |
别名 | DGSX, Glypican 3, GPC3, GTR2 2, Intestinal protein OCI 5, MXR7, OCI 5, OCI5, SDYS, SGB, SGBS, SGBS1 |
Uniprot ID | P51654 |
免疫原 | 人Glypican 3重组蛋白 |
抗体亚型 | IgG1, κ |
克隆号 | SB579 |
纯化方式 | 亲和纯化 |
亚细胞定位 | 细胞膜 |
应用
| 应用 | 物种 | 稀释 | 阳性样品 |
| IHC/IF 免疫组织化学/免疫荧光 | 人 | 1: 500-1: 1000 | 肝癌, 肝, 肝癌旁 |
背景
Cell surface proteoglycan that bears heparan sulfate . Negatively regulates the hedgehog signaling pathway when attached via the GPI-anchor to the cell surface by competing with the hedgehog receptor PTC1 for binding to hedgehog proteins Binding to the hedgehog protein SHH triggers internalization of the complex by endocytosis and its subsequent lysosomal degradation Positively regulates the canonical Wnt signaling pathway by binding to the Wnt receptor Frizzled and stimulating the binding of the Frizzled receptor to Wnt ligands . Positively regulates the non-canonical Wnt signaling pathway Binds to CD81 which decreases the availability of free CD81 for binding to the transcriptional repressor HHEX, resulting in nuclear translocation of HHEX and transcriptional repression
图像
| IHC检测Glypican 3蛋白(货号 GB155529). 样品: 人肝癌, 4%多聚甲醛 (货号G1101) 固定12-24小时. 抗原修复: 抗原修复仪 (货号 ARI-4),Tris-EDTA抗原修复液(pH 9.0) (货号G1203), 水浴100℃, 25分钟. —抗: 1: 500稀释, 4℃ 孵育过夜. 二抗: S-vision免疫组化多聚二抗(山羊抗小鼠), 即用型(货号G1301), 室温孵育20分钟. |
| IHC检测Glypican 3蛋白(货号 GB155529). 样品: 人肝癌, 4%多聚甲醛 (货号G1101) 固定12-24小时. 抗原修复: 抗原修复仪 (货号 ARI-4),Tris-EDTA抗原修复液(pH 9.0) (货号G1203), 水浴100℃, 25分钟. —抗: 1: 500稀释, 4℃ 孵育过夜. 二抗: S-vision免疫组化多聚二抗(山羊抗小鼠), 即用型(货号G1301), 室温孵育20分钟. |
| IHC检测Glypican 3蛋白(货号 GB155529). 样品: 人肝癌, 4%多聚甲醛 (货号G1101) 固定12-24小时. 抗原修复: 抗原修复仪 (货号 ARI-4),Tris-EDTA抗原修复液(pH 9.0) (货号G1203), 水浴100℃, 25分钟. —抗: 1: 500稀释, 4℃ 孵育过夜. 二抗: S-vision免疫组化多聚二抗(山羊抗小鼠), 即用型(货号G1301), 室温孵育20分钟. |
| IHC检测Glypican 3蛋白(货号 GB155529). 样品: 人肝癌, 4%多聚甲醛 (货号G1101) 固定12-24小时. 抗原修复: 抗原修复仪 (货号 ARI-4),Tris-EDTA抗原修复液(pH 9.0) (货号G1203), 水浴100℃, 25分钟. —抗: 1: 500稀释, 4℃ 孵育过夜. 二抗: S-vision免疫组化多聚二抗(山羊抗小鼠), 即用型(货号G1301), 室温孵育20分钟. |
| IHC检测Glypican 3蛋白(货号 GB155529). 样品: 人肝癌, 4%多聚甲醛 (货号G1101) 固定12-24小时. 抗原修复: 抗原修复仪 (货号 ARI-4),Tris-EDTA抗原修复液(pH 9.0) (货号G1203), 水浴100℃, 25分钟. —抗: 1: 500稀释, 4℃ 孵育过夜. 二抗: S-vision免疫组化多聚二抗(山羊抗小鼠), 即用型(货号G1301), 室温孵育20分钟. |
| IHC检测Glypican 3蛋白(货号 GB155529). 样品: 人肝癌旁, 4%多聚甲醛 (货号G1101) 固定12-24小时. 抗原修复: 抗原修复仪 (货号 ARI-4),Tris-EDTA抗原修复液(pH 9.0) (货号G1203), 水浴100℃, 25分钟. —抗: 1: 500稀释, 4℃ 孵育过夜. 二抗: S-vision免疫组化多聚二抗(山羊抗小鼠), 即用型(货号G1301), 室温孵育20分钟. |
| IHC检测Glypican 3蛋白(货号 GB155529). 样品: 人肝癌, 4%多聚甲醛 (货号G1101) 固定12-24小时. 抗原修复: 抗原修复仪 (货号 ARI-4),Tris-EDTA抗原修复液(pH 9.0) (货号G1203), 水浴100℃, 25分钟. —抗: 1: 500稀释, 4℃ 孵育过夜. 二抗: S-vision免疫组化多聚二抗(山羊抗小鼠), 即用型(货号G1301), 室温孵育20分钟. |
储存
| 储存条件 | 在-20℃下储存一年, 避免反复冻融. |
| 储存缓冲液 | 含0.15% ProClin300防腐剂, 100 μg/mL牛血清白蛋白和50%甘油的磷酸盐缓冲液. |
注意:
1.本产品仅供研究使用.
2.建议用一抗稀释液(G2025)稀释本产品.
| 货号 | 名称 | 规格 | 价格 | 操作 |
|---|
| 货号 | 名称 | 规格 | 价格 | 操作 |
|---|